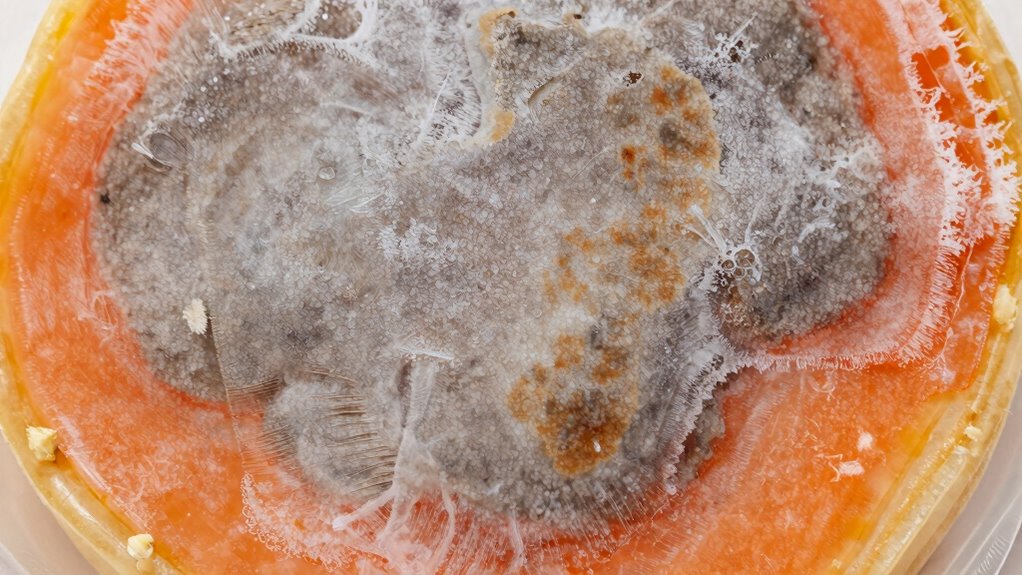
identify visual texture changes

Freezer burn happens when your food gets exposed to air over time, causing dehydration, oxidation, and texture changes. The quick fix most people skip is removing excess air from packaging—using vacuum seals, airtight wraps, or tightly pressed bags—before freezing. This simple step creates a barrier that prevents moisture loss and freezer burn. If you keep this in mind, you’ll protect your food better; discover more ways to keep your food fresh and flavorful.
Key Takeaways
- Proper packaging, like vacuum sealing or airtight wraps, prevents air exposure that causes freezer burn.
- Maintaining a consistent freezer temperature of 0°F (-18°C) is essential to stop dehydration and oxidation.
- Removing excess air before sealing food reduces moisture loss and ice crystal formation.
- Label and date foods to ensure timely use, minimizing prolonged storage that leads to freezer burn.
- Thaw foods gradually in the refrigerator or cold water to preserve texture and prevent further damage.

Vacuum Sealer Machine 75KPa Food with 6-in-1 Dry/Moist Modes & Digital Timer, Compact Lightweight Design, Built-in Cutter + 10 Bags (Black Silver)
【6-in-1 Includes Cutter Functions】Moist & Dry Modes – Maximize freshness for different types of food; Vac Seal- One…
As an affiliate, we earn on qualifying purchases.
As an affiliate, we earn on qualifying purchases.
What Is Freezer Burn and How Does It Happen?

Freezer burn occurs when frozen food is exposed to air over time, causing dehydration and oxidation. The main factors are maintaining a proper freezer temperature and using effective packaging materials. If your freezer isn’t cold enough—ideally 0°F (-18°C)—air can cause moisture loss, leading to freezer burn. Packaging materials play an essential role; airtight, moisture-proof wraps or containers prevent air from reaching the food’s surface. Thin or damaged packaging allows air infiltration, accelerating dehydration and oxidation. Properly sealed packages help lock in moisture and preserve quality. Regularly checking your freezer’s temperature and replacing damaged packaging keeps your food protected. Using electric freezers with precise temperature controls can further reduce the risk of freezer burn. Additionally, understanding proper storage techniques can enhance preservation and prevent quality loss. Implementing proper labeling can also help monitor storage times and prevent unnecessary freezer burn. Maintaining consistent freezer temperatures is crucial for avoiding fluctuations that can lead to dehydration and spoilage. By controlling these factors, you reduce the risk of freezer burn and extend the freshness of your frozen foods.

Glad Press'N Seal Food Plastic Wrap, 70 Square Foot Roll (Package May Vary)
PRESS'N SEAL PLASTIC FOOD WRAP: With a quick press and glide, this food wrap keeps food fresh with…
As an affiliate, we earn on qualifying purchases.
As an affiliate, we earn on qualifying purchases.
How to Recognize Signs of Freezer Burn on Your Food
When freezer burn occurs, it leaves visible and textural clues that can help you identify affected food. Look for visual signs such as white or grayish patches, which often appear as dry, leathery spots on the surface. These discolorations indicate dehydration caused by air reaching the food’s surface. Texture changes are also telltale signs; foods might feel dry, tough, or shriveled compared to their fresh state. You may notice icy crystals or frost on the packaging or food itself, further signaling freezer burn. Keep an eye out for these visual signs and texture differences, especially on exposed or poorly wrapped items. Recognizing these cues early helps you decide whether the food is still usable or if it’s best to discard it to avoid compromised quality. Proper storage techniques, such as airtight packaging, can also help prevent freezer burn and extend the freshness of your foods. Additionally, understanding freezer burn causes can aid in developing better storage habits to minimize its occurrence. Being aware of freezer burn prevention strategies can save you time and money by maintaining the quality of your frozen goods.

2 Pack Refrigerator Thermometer, 30-30°C/20-80°F, Classic Fridge Thermometer Large Dial with Red Indicator Thermometer for Freezer Refrigerator Cooler
Convenient and practical: Our refrigerator thermometer is suitable for traditional refrigerators, freezers, insulated boxes, etc. It has a…
As an affiliate, we earn on qualifying purchases.
As an affiliate, we earn on qualifying purchases.
How Freezer Burn Damages Food Quality and Depletes Nutrients

Freezer burn can cause your food to lose essential nutrients, reducing its overall health value. It also damages the texture and flavor, making your meals less enjoyable. Recognizing these effects helps you protect your food’s quality and maximize its nutritional benefits. To prevent this, proper storage techniques preserve food quality and understanding how freezer burn occurs are essential steps in maintaining the healthfulness of your frozen foods. Using reliable backup power solutions can also help ensure your freezer remains operational during power outages, preventing freezer burn caused by temperature fluctuations. Being aware of air quality factors that influence food preservation can further enhance your efforts to keep your frozen foods fresh and nutritious. Additionally, understanding modern kitchen technology can offer innovative solutions to monitor and control storage conditions more effectively. Regularly checking your freezer’s temperature with a thermometer can help maintain optimal storage conditions and prevent freezer burn.
Nutrient Loss During Freezing
Have you ever noticed that frozen foods sometimes lose their flavor or texture over time? That’s partly due to nutrient loss during freezing. When you don’t use proper freezing techniques, essential vitamins and minerals degrade faster. Here’s how it happens:
- Ice Crystal Formation: Larger crystals damage cell walls, releasing nutrients.
- Air Exposure: Oxygen accelerates oxidation, depleting nutrients.
- Extended Storage: The longer food stays frozen, the more nutrients diminish.
- Temperature Fluctuations: Repeated thawing and refreezing worsen nutrient degradation.
- Smart Freezing: Using proper freezing techniques like quick freezing and airtight packaging helps lock in vitamins and minerals, ensuring your food stays nutrient-rich and nutritious longer. Proper methods make all the difference in maintaining food quality during freezing.
Texture and Flavor Damage
Freezer burn occurs when exposed to air, causing dehydration and ice crystal formation that directly damage the food’s surface. This damage leads to texture degradation, making foods feel dry, tough, or grainy when you cook or eat them. The affected areas often become less tender and lose their original mouthfeel. Additionally, freezer burn causes flavor deterioration, as the exposed surfaces absorb odors and lose their natural taste. Over time, this results in bland, stale, or off-flavored food, diminishing your eating experience. The combination of texture and flavor damage not only reduces the enjoyment of your meals but can also make leftovers less appealing. Proper packaging and quick freezing are essential to prevent these issues and preserve your food’s quality. Understanding the importance of plant properties and correct storage techniques can help you maintain food freshness and nutritional value for longer periods. Proper food preservation techniques can significantly minimize the risk of freezer burn and extend the lifespan of your frozen goods. Additionally, storage techniques, such as using airtight containers, help minimize exposure to air, further reducing the risk of freezer burn. Incorporating energetic alignment practices into your food storage routines can also promote better preservation and overall food quality.

FoodSaver Custom Length Vacuum Sealer Bags Multipack, 5 Count Rolls for Airtight Food Storage and Sous Vide – Compatible with FoodSaver, 8 (2 Pack) and 11 (3 Pack)
Made in USA: Proudly manufactured in the United States
As an affiliate, we earn on qualifying purchases.
As an affiliate, we earn on qualifying purchases.
A 10-Second Trick to Prevent Freezer Burn Before It Starts

To prevent freezer burn before it starts, simply squeeze out as much air as possible from your storage bags or containers. This minimizes exposure to oxygen, which can cause dehydration and ice crystal formation. Here are four quick tips to help:
Squeeze out excess air from storage bags to prevent freezer burn and preserve freshness.
- Adjust the freezer temperature to 0°F (-18°C) or lower to slow spoilage.
- Use airtight bags or containers to create a tight seal.
- Label your packages with date and contents for better management of storage duration.
- Remove excess air by pressing out as much as you can before sealing.
- Ensuring proper storage conditions can significantly extend the freshness of your frozen foods, and understanding food preservation techniques can help you optimize your food preservation techniques.
How to Pack Food Properly to Avoid Freezer Burn

To prevent freezer burn, you need to pack your food correctly. Use proper wrapping techniques and airtight containers to keep moisture out. Don’t forget to label and date everything so you use the oldest items first. Ensuring your packaging is airtight and properly sealed can significantly reduce exposure to air, which is a key factor in freezer burn. Additionally, choosing appropriate packaging materials designed specifically for freezing can help maintain food quality over time. Understanding the role of food preservation techniques can also help you select the best methods for extending the freshness of your frozen items.
Proper Wrapping Techniques
Proper wrapping is essential for preventing freezer burn, and how you pack your food makes a big difference. To ensure maximum protection, consider these techniques:
- Use vacuum sealing to remove air and create an airtight barrier, which markedly reduces moisture loss.
- Opt for silicone wraps to mold tightly around irregularly shaped items, preventing air pockets.
- Wrap foods tightly with plastic wrap or aluminum foil before placing them in freezer bags for added insulation.
- Remove as much air as possible before sealing; excess air accelerates freezer burn.
Use Airtight Containers
Using airtight containers is one of the most effective ways to prevent freezer burn because they create a sealed environment that keeps moisture in and air out. By storing food in these containers, you minimize exposure to oxygen, which causes dehydration and ice crystal formation. For extra protection, consider vacuum sealing before placing items into airtight containers; this reduces air and extends freshness. Here’s a quick comparison:
| Method | Benefits |
|---|---|
| Airtight containers | Easy to use, reusable, prevents moisture loss |
| Vacuum sealing | Removes air, prolongs storage life |
| Combination | Best for long-term preservation |
| Resealable bags | Convenient, but less durable |
| Standard wrapping | Least effective for freezer storage |
Label and Date Food
Label and date your food before placing it in the freezer to keep track of storage times and prevent unnecessary waste. Proper food labeling with clear descriptions helps you quickly identify contents, while date tracking ensures you use items before they spoil. To do this effectively:
- Write the food name clearly on the container or bag.
- Include the date you’re freezing it.
- Use permanent markers or labels for durability.
- Organize items by dates to prioritize older foods first.
This system minimizes freezer burn risks by encouraging timely use of stored food. Accurate food labeling and date tracking make it easier to avoid keeping items too long, which can lead to freezer burn and loss of quality. Staying organized helps you save money and reduces food waste.
Tips for Thawing Food Safely and Avoiding Further Damage

To prevent further damage and guarantee food safety, it’s vital to thaw frozen items carefully. Always opt for safe thawing methods, like transferring food to the refrigerator, which allows for slow, even defrosting. This minimizes the risk of bacterial growth and helps maintain food quality. If you’re in a hurry, quick defrosting using cold water or the microwave is safe as long as you cook the food immediately afterward. Avoid thawing at room temperature, as this encourages bacteria to multiply quickly. Keep food in its original packaging or place it in a leak-proof bag to prevent cross-contamination. By following these tips, you ensure your food stays safe and preserves its texture and flavor during the thawing process.
Common Freezer Storage Mistakes That Cause Burn

One common mistake that leads to freezer burn is failing to properly package food before storage. Without airtight packaging, moisture escapes, causing dehydration and ice crystals. To avoid this, guarantee you:
- Use airtight containers or heavy-duty freezer bags to seal food tightly.
- Remove excess air before sealing to prevent moisture loss.
- Properly label packages with clear, accurate information to track storage time.
- Avoid overloading your freezer, which restricts airflow and promotes uneven freezing.
Neglecting these steps allows air to reach the food, increasing burn risk. Proper labeling helps you use items before they become freezer-burned. By focusing on airtight packaging and consistent labeling, you minimize moisture loss and extend food quality in your freezer.
Organizing Your Freezer to Reduce Freezer Burn Risks

Organizing your freezer effectively can considerably reduce the risk of freezer burn by ensuring proper airflow and easy access to stored items. Good freezer organization involves using strategic storage techniques, such as grouping similar items and labeling containers. Keep frequently used foods near the front to minimize unnecessary door openings, which can cause temperature fluctuations. Use clear containers and stack items neatly to maximize space and visibility. Proper storage techniques help maintain a consistent temperature, preventing freezer burn. Consider the table below for quick tips:
| Freezer Organization | Storage Techniques |
|---|---|
| Group similar foods | Use airtight containers |
| Label everything | Keep perishables at the front |
| Maintain space for airflow | Avoid overstuffing |
Efficient freezer organization minimizes exposure to air and temperature changes, protecting your food.
When and How to Save Food Affected by Freezer Burn

Knowing when and how to save food affected by freezer burn can help you reduce waste and recover the quality of your stored items. First, assess the extent of freezer burn—if it’s minor, you can often salvage the food. Next, follow these steps:
- Trim off the freezer-burned areas with a sharp knife.
- Rinse the remaining food quickly to remove any surface ice or dehydration.
- Repackage it tightly in fresh, airtight packaging to prevent further freezer burn.
- Return it to proper food storage, maintaining consistent freezer temperatures and regular freezer maintenance.
This approach minimizes waste and extends the usability of your food. Remember, freezer maintenance and good food storage habits are key to preventing future damage and keeping your frozen foods in top shape.
Frequently Asked Questions
Can Freezer Burn Make Food Unsafe to Eat?
Freezer burn doesn’t make food unsafe to eat, but it can affect taste and texture. For food safety, it’s best to follow proper storage techniques, like airtight packaging, to prevent freezer burn. If your food has extensive freezer burn, it might be less appealing, but it’s generally still safe. Always check for off smells or colors to ensure safety, and discard if anything seems suspicious.
Does Freezer Burn Affect All Types of Food Equally?
Freezer burn doesn’t affect all food types equally. You notice more damage on foods with higher moisture content, like fruits and meats, because they lose more moisture and develop dry, leathery patches. Drier foods, such as bread or baked goods, typically resist freezer burn better. The variation in moisture content causes different levels of damage, so your food’s type and texture determine how much freezer burn impacts it.
How Long Can Food Stay in the Freezer Before Freezer Burn Occurs?
You can usually store food in the freezer for 3 to 12 months before freezer burn starts to affect its quality. Proper freezer storage is key to prolonging food longevity; make sure to wrap items tightly and remove excess air. For best results, label your food with storage dates. Regularly check your freezer to make sure of consistent temperatures, which helps prevent freezer burn and keeps your food fresh longer.
Are There Any Foods That Are Resistant to Freezer Burn?
Like a knight in shining armor, some freeze resistant foods stand strong against freezer burn myths. You’ll find that high-fat foods, like certain cheeses and fatty cuts of meat, resist freezer burn better than others. Additionally, foods with natural oils or sugars, such as nuts or berries, are more resistant. Keep in mind, no food is completely immune, but proper packaging helps. You’re in control of keeping your food fresh and freezer burn at bay!
Can You Reverse Freezer Burn on Already Affected Food?
You can’t fully reverse freezer burn on already affected food, but you can try edible recovery methods to minimize its effects. Trim off any freezer-burned areas and rehydrate the food with moisture or marinade. While this won’t restore perfect texture or flavor, it helps make the food more palatable. Keep in mind that reversing effects is limited, and prevention remains the best way to maintain quality.
Conclusion
To keep your food fresh and flavorful, don’t overlook that quick 10-second fix before freezing. For example, imagine you’re packing leftovers for the week—adding a simple plastic wrap layer can prevent freezer burn and save you from wasting spoiled food. By properly packing, organizing, and thawing your items, you’ll maintain quality and nutrients. Taking these small steps guarantees your frozen foods stay just as tasty as when you first stored them.









